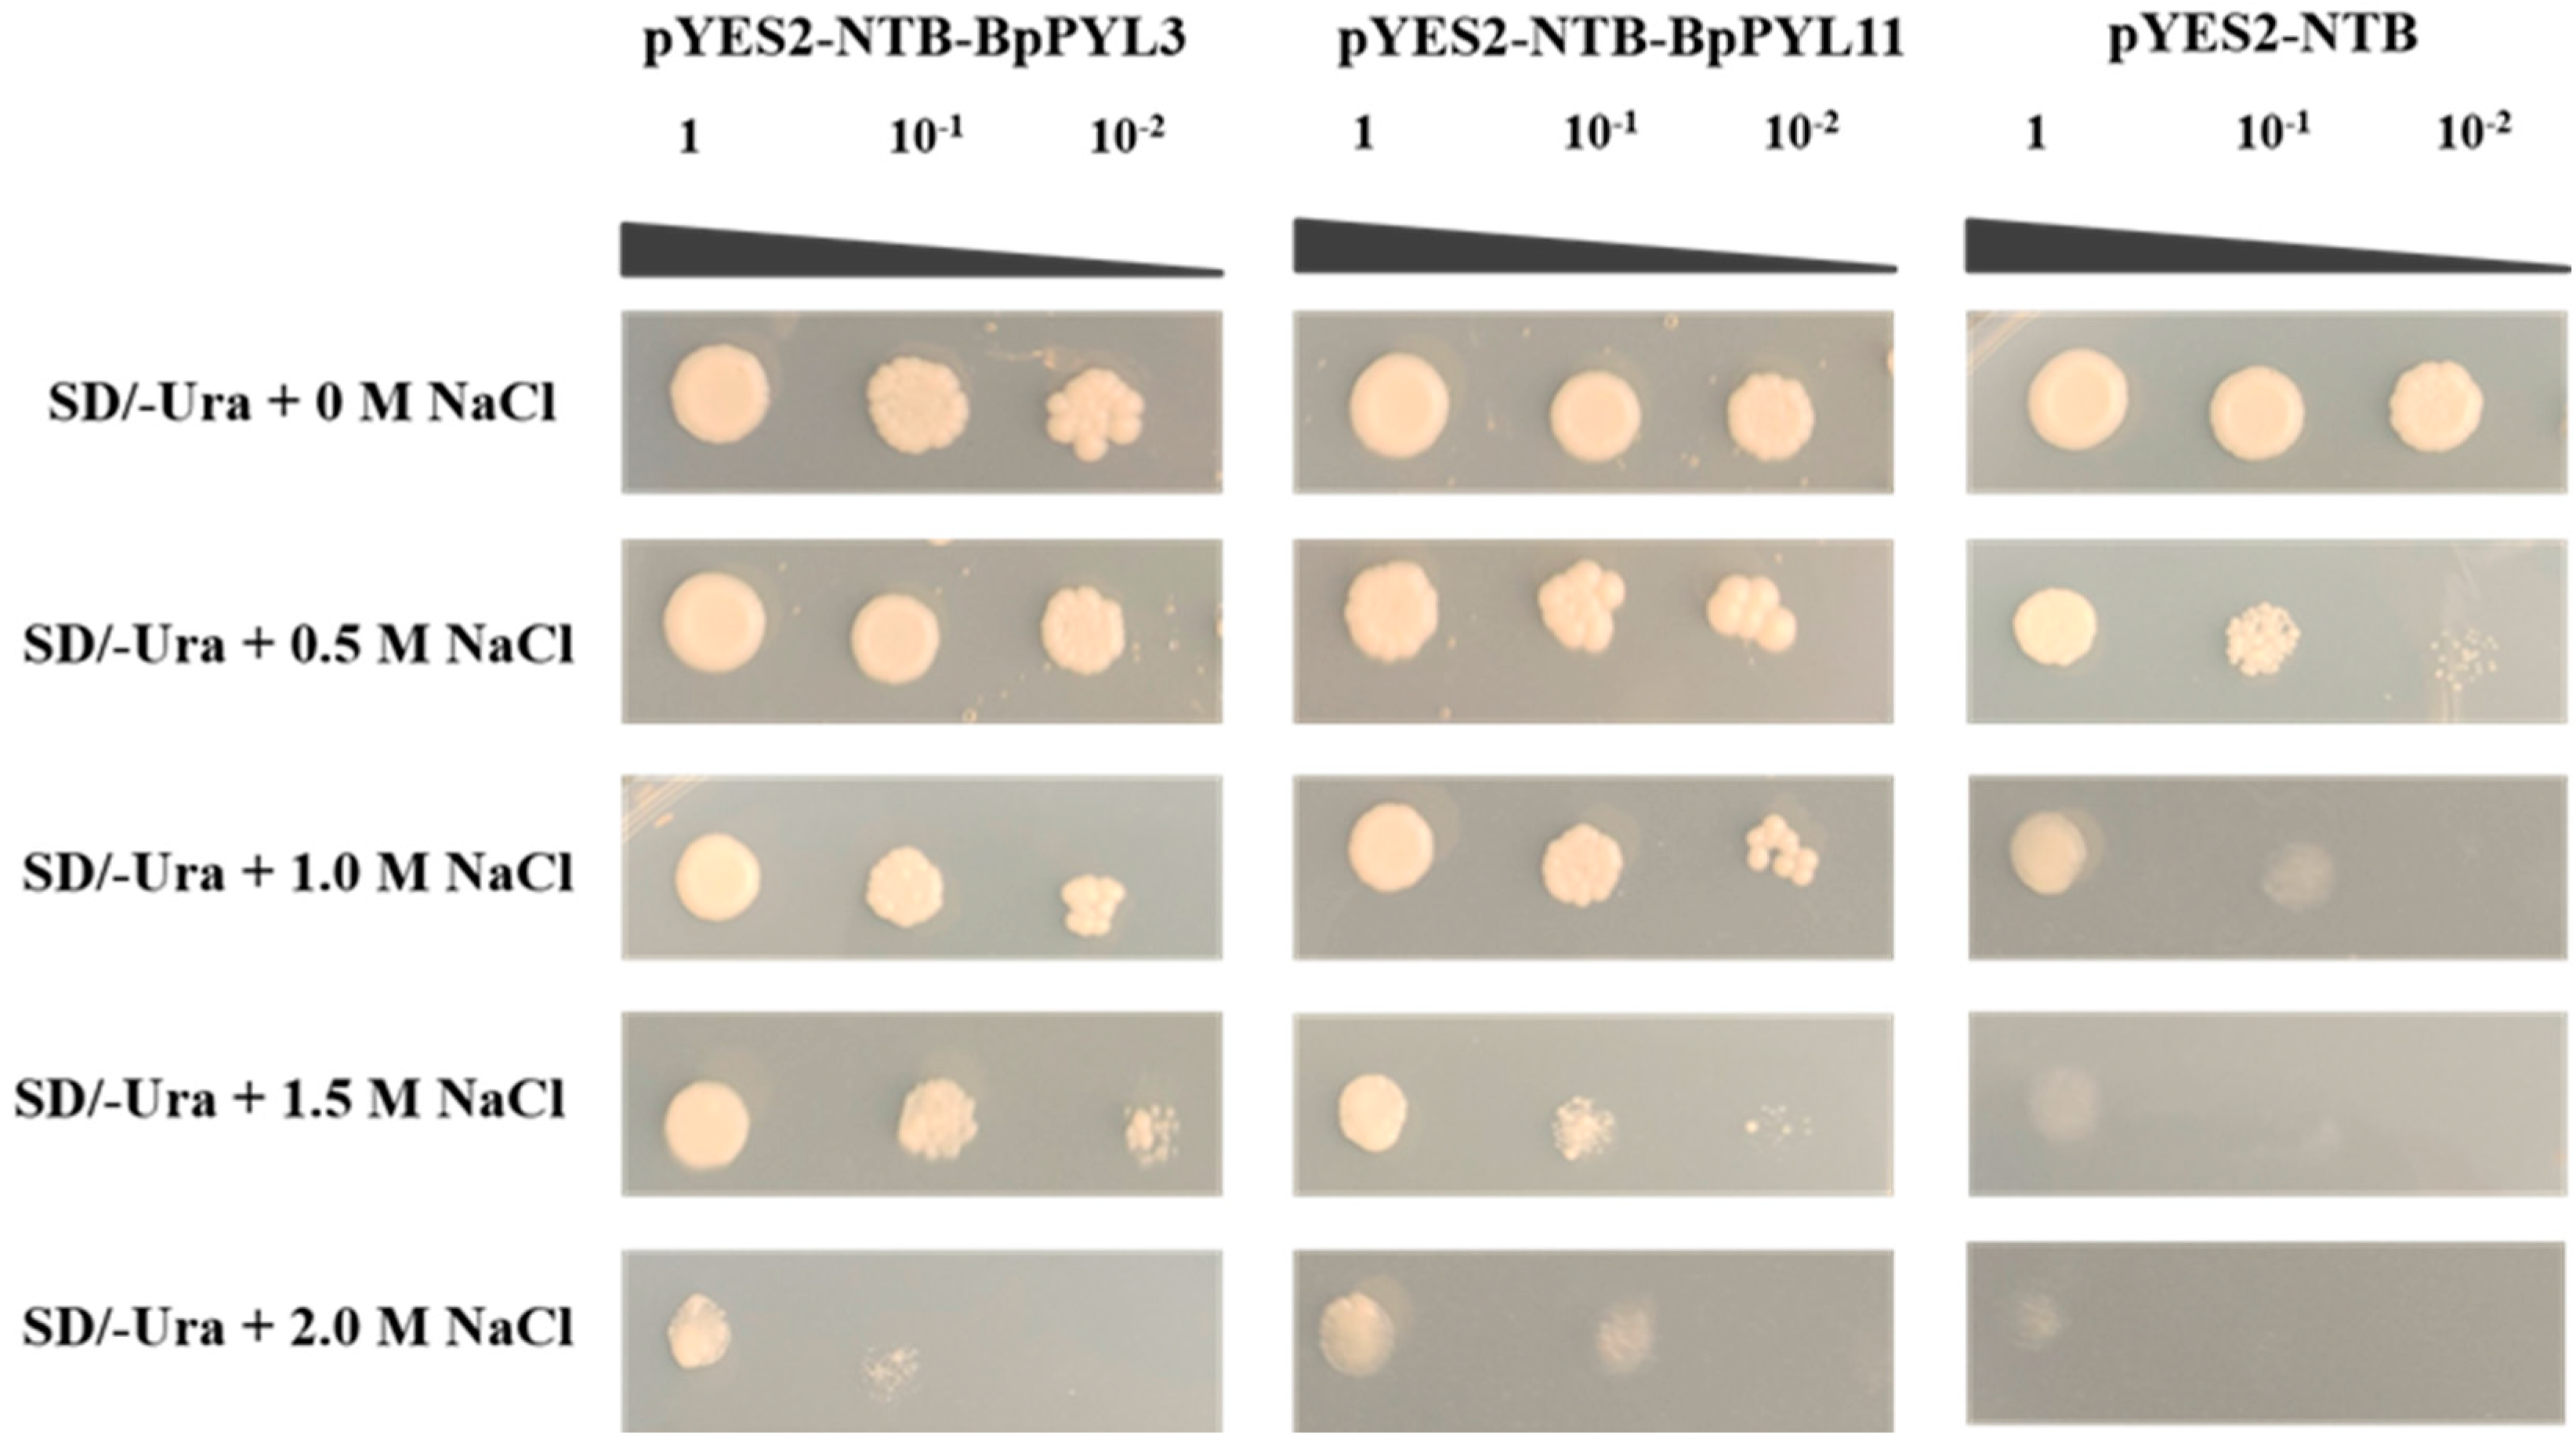
Ijms 25 13728 g013

Genome-Wide Analysis of the PYL Gene Family in Betula platyphylla and Its Responses to Abiotic Stresses
Abstract
1. Introduction
2. Results
2.1. Identification, Chromosome Localization, and Physiochemical Properties of PYL Genes in Birch
2.2. Phylogenetic Relationships and Gene Structures of BpPYLs
2.3. Syntenic Relationships of BpPYLs
2.4. Cis-Acting Elements in the Promoters of BpPYLs
2.5. Enriched Pathways of BpPYLs Functioning
2.6. Tissue-Specific Expression Patterns of BpPYLs
2.7. Expression Patterns of BpPYLs Under ABA Treatment
2.8. Expression Patterns of BpPYLs Under Salt Treatment
2.9. Expression Patterns of BpPYLs Under PEG Treatment
2.10. Positive Functions of BpPYL3 and BpPYL11 in Salt Tolerance
3. Discussion
4. Materials and Methods
4.1. Genome-Wide Identification and Physiochemical Analysis of PYL Members in Birch
4.2. Phylogenetic Analysis of PYLs from Birch, Arabidopsis, and Rice
4.3. Gene Structure Analysis of BpPYLs
4.4. Intraspecific and Interspecific Synteny Analysis
4.5. cis-Acting Elements Analysis
4.6. GO Enrichment and KEGG Analysis
4.7. Plant Materials and Treatments
4.8. Expression Analysis and Data Processing
4.9. Salt-Tolerant Yeast Transformation
5. Conclusions
Supplementary Materials
Author Contributions
Funding
Institutional Review Board Statement
Informed Consent Statement
Data Availability Statement
Acknowledgments
Conflicts of Interest
References
- Finkelstein, R.R.; Rock, C.D. Abscisic Acid Biosynthesis and Response. Arab. Book 2002, 1, 137–138. [Google Scholar] [CrossRef] [PubMed]
- Cutler, S.R.; Rodriguez, P.L.; Finkelstein, R.R.; Abrams, S.R. Abscisic Acid: Emergence of a Core Signaling Network. Annu. Rev. Plant Biol. 2010, 61, 651–679. [Google Scholar] [CrossRef]
- Lumba, S.; Cutler, S.; McCourt, P. Plant Nuclear Hormone Receptors: A Role for Small Molecules in Protein-Protein Interactions. Annu. Rev. Cell Dev. Biol. 2010, 26, 445–469. [Google Scholar] [CrossRef] [PubMed]
- Nambara, E.; Marion-Poll, A. Abscisic Acid Biosynthesis and Catabolism. Annu. Rev. Plant Biol. 2005, 56, 165–185. [Google Scholar] [CrossRef] [PubMed]
- Zhu, J. Abiotic Stress Signaling and Responses in Plants. Cell 2016, 167, 313–324. [Google Scholar] [CrossRef]
- Weng, J.-K.; Ye, M.; Li, B.; Noel, J.P. Co-evolution of Hormone Metabolism and Signaling Networks Expands Plant Adaptive Plasticity. Cell 2016, 166, 881–893. [Google Scholar] [CrossRef] [PubMed]
- Xing, L.; Zhao, Y.; Gao, J.; Xiang, C.; Zhu, J.-K. The ABA receptor PYL9 together with PYL8 plays an important role in regulating lateral root growth. Sci. Rep. 2016, 6, 27177. [Google Scholar] [CrossRef] [PubMed]
- Zhu, J.-K. Salt and Drought Stress Signal Transduction in Plants. Annu. Rev. Plant Biol. 2002, 53, 247–273. [Google Scholar] [CrossRef] [PubMed]
- Yang, Z.; Liu, J.; Tischer, S.V.; Christmann, A.; Windisch, W.; Schnyder, H.; Grill, E. Leveraging abscisic acid receptors for efficient water use in Arabidopsis. Proc. Natl. Acad. Sci. USA 2016, 113, 6791–6796. [Google Scholar] [CrossRef] [PubMed]
- Zhao, Y.; Gao, J.; Im Kim, J.; Chen, K.; Bressan, R.A.; Zhu, J.-K. Control of Plant Water Use by ABA Induction of Senescence and Dormancy: An Overlooked Lesson from Evolution. Plant Cell Physiol. 2017, 58, 1319–1327. [Google Scholar] [CrossRef] [PubMed]
- Huang, X.; Shi, H.; Hu, Z.; Liu, A.; Amombo, E.; Chen, L.; Fu, J. ABA Is Involved in Regulation of Cold Stress Response in Bermudagrass. Front. Plant Sci. 2017, 8, 1613. [Google Scholar] [CrossRef] [PubMed]
- Sripinyowanich, S.; Klomsakul, P.; Boonburapong, B.; Bangyeekhun, T.; Asami, T.; Gu, H.; Buaboocha, T.; Chadchawan, S. Exogenous ABA induces salt tolerance in indica rice (Oryza sativa L.): The role of OsP5CS1 and OsP5CR gene expression during salt stress. Environ. Exp. Bot. 2013, 86, 94–105. [Google Scholar] [CrossRef]
- Zandalinas, S.I.; Balfagón, D.; Arbona, V.; Gómez-Cadenas, A.; Inupakutika, M.A.; Mittler, R. ABA is required for the accumulation of APX1 and MBF1c during a combination of water deficit and heat stress. J. Exp. Bot. 2016, 67, 5381–5390. [Google Scholar] [CrossRef]
- Tremblay, M.F.; Nadeau, P.; Lalonde, M. Effect of ABA on freezing resistance of Betula papyrifera and Alnus incana woody plant cell suspensions. Tree Physiol. 1992, 10, 317–326. [Google Scholar] [CrossRef]
- Assmann, S.M.; Jegla, T. Guard cell sensory systems: Recent insights on stomatal responses to light, abscisic acid, and CO2. Curr. Opin. Plant Biol. 2016, 33, 157–167. [Google Scholar] [CrossRef]
- Ma, Y.; Szostkiewicz, I.; Korte, A.; Moes, D.; Yang, Y.; Christmann, A.; Grill, E. Regulators of PP2C Phosphatase Activity Function as Abscisic Acid Sensors. Science 2009, 324, 1064–1068. [Google Scholar] [CrossRef] [PubMed]
- Fujii, H.; Chinnusamy, V.; Rodrigues, A.; Rubio, S.; Antoni, R.; Park, S.-Y.; Cutler, S.R.; Sheen, J.; Rodriguez, P.L.; Zhu, J.-K. In vitro reconstitution of an abscisic acid signalling pathway. Nature 2009, 462, 660–664. [Google Scholar] [CrossRef] [PubMed]
- Santiago, J.; Dupeux, F.; Round, A.; Antoni, R.; Park, S.-Y.; Jamin, M.; Cutler, S.R.; Rodriguez, P.L.; Márquez, J.A. The abscisic acid receptor PYR1 in complex with abscisic acid. Nature 2009, 462, 665–668. [Google Scholar] [CrossRef]
- Melcher, K.; Ng, L.-M.; Zhou, X.E.; Soon, F.-F.; Xu, Y.; Suino-Powell, K.M.; Park, S.-Y.; Weiner, J.J.; Fujii, H.; Chinnusamy, V.; et al. A gate–latch–lock mechanism for hormone signalling by abscisic acid receptors. Nature 2009, 462, 602–608. [Google Scholar] [CrossRef]
- Miyakawa, T.; Fujita, Y.; Yamaguchi-Shinozaki, K.; Tanokura, M. Structure and function of abscisic acid receptors. Trends Plant Sci. 2013, 18, 259–266. [Google Scholar] [CrossRef] [PubMed]
- Santiago, J.; Rodrigues, A.; Saez, A.; Rubio, S.; Antoni, R.; Dupeux, F.; Park, S.Y.; Márquez, J.A.; Cutler, S.R.; Rodriguez, P.L. Modulation of drought resistance by the abscisic acid receptor PYL5 through inhibition of clade A PP2Cs. Plant J. 2009, 60, 575–588. [Google Scholar] [CrossRef]
- Johnson, R.R.; Wagner, R.L.; Verhey, S.D.; Walker-Simmons, M.K. The Abscisic Acid-Responsive Kinase PKABA1 Interacts with a Seed-Specific Abscisic Acid Response Element-Binding Factor, TaABF, and Phosphorylates TaABF Peptide Sequences. Plant Physiol. 2002, 130, 837–846. [Google Scholar] [CrossRef]
- Kobayashi, Y.; Murata, M.; Minami, H.; Yamamoto, S.; Kagaya, Y.; Hobo, T.; Yamamoto, A.; Hattori, T. Abscisic acid-activated SNRK2 protein kinases function in the gene-regulation pathway of ABA signal transduction by phosphorylating ABA response element-binding factors. Plant J. 2005, 44, 939–949. [Google Scholar] [CrossRef] [PubMed]
- Furihata, T.; Maruyama, K.; Fujita, Y.; Umezawa, T.; Yoshida, R.; Shinozaki, K.; Yamaguchi-Shinozaki, K. Abscisic acid-dependent multisite phosphorylation regulates the activity of a transcription activator AREB1. Proc. Natl. Acad. Sci. USA 2006, 103, 1988–1993. [Google Scholar] [CrossRef] [PubMed]
- Hao, Q.; Yin, P.; Li, W.; Wang, L.; Yan, C.; Lin, Z.; Wu, J.Z.; Wang, J.; Yan, S.F.; Yan, N. The Molecular Basis of ABA-Independent Inhibition of PP2Cs by a Subclass of PYL Proteins. Mol. Cell 2011, 42, 662–672. [Google Scholar] [CrossRef]
- Yin, P.; Fan, H.; Hao, Q.; Yuan, X.; Wu, D.; Pang, Y.; Yan, C.; Li, W.; Wang, J.; Yan, N. Structural insights into the mechanism of abscisic acid signaling by PYL proteins. Nat. Struct. Mol. Biol. 2009, 16, 1230–1236. [Google Scholar] [CrossRef] [PubMed]
- Bai, G.; Xie, H.; Yao, H.; Li, F.; Chen, X.; Zhang, Y.; Xiao, B.; Yang, J.; Li, Y.; Yang, D.-H. Genome-wide identification and characterization of ABA receptor PYL/RCAR gene family reveals evolution and roles in drought stress in Nicotiana tabacum. BMC Genom. 2019, 20, 575. [Google Scholar] [CrossRef]
- Yadav, S.K.; Santosh Kumar, V.V.; Verma, R.K.; Yadav, P.; Saroha, A.; Wankhede, D.P.; Chaudhary, B.; Chinnusamy, V. Genome-wide identification and characterization of ABA receptor PYL gene family in rice. BMC Genom. 2020, 21, 676. [Google Scholar] [CrossRef]
- Bai, G.; Yang, D.-H.; Zhao, Y.; Ha, S.; Yang, F.; Ma, J.; Gao, X.-S.; Wang, Z.-M.; Zhu, J.-K. Interactions between soybean ABA receptors and type 2C protein phosphatases. Plant Mol. Biol. 2013, 83, 651–664. [Google Scholar] [CrossRef] [PubMed]
- González-Guzmán, M.; Rodríguez, L.; Lorenzo-Orts, L.; Pons, C.; Sarrión-Perdigones, A.; Fernández, M.A.; Peirats-Llobet, M.; Forment, J.; Moreno-Alvero, M.; Cutler, S.R.; et al. Tomato PYR/PYL/RCAR abscisic acid receptors show high expression in root, differential sensitivity to the abscisic acid agonist quinabactin, and the capability to enhance plant drought resistance. J. Exp. Bot. 2014, 65, 4451–4464. [Google Scholar] [CrossRef] [PubMed]
- Ma, W.; Gordon, C.S.; Rajagopalan, N.; Risseeuw, E.P.; Surpin, M.; Ball, F.J.; Barber, C.J.; Buhrow, L.M.; Clark, S.M.; Page, J.E.; et al. Characterization of Triticum aestivum Abscisic Acid Receptors and a Possible Role for These in Mediating Fusairum Head Blight Susceptibility in Wheat. PLoS ONE 2016, 11, e0164996. [Google Scholar] [CrossRef]
- Fan, W.; Zhao, M.; Li, S.; Bai, X.; Li, J.; Meng, H.; Mu, Z. Contrasting transcriptional responses of PYR1/PYL/RCAR ABA receptors to ABA or dehydration stress between maize seedling leaves and roots. BMC Plant Biol. 2016, 16, 99. [Google Scholar] [CrossRef]
- Di, F.; Jian, H.; Wang, T.; Chen, X.; Ding, Y.; Du, H.; Lu, K.; Li, J.; Liu, L. Genome-Wide Analysis of the PYL Gene Family and Identification of PYL Genes That Respond to Abiotic Stress in Brassica napus. Genes 2018, 9, 156. [Google Scholar] [CrossRef] [PubMed]
- Chai, Y.-m.; Zhang, Q.; Tian, L.; Li, C.-L.; Xing, Y.; Qin, L.; Shen, Y.-Y. Brassinosteroid is involved in strawberry fruit ripening. Plant Growth Regul. 2012, 69, 63–69. [Google Scholar] [CrossRef]
- Wu, K.; Yu, J.; Yang, L.; Liu, X.; Tang, R.; Wang, Y.; Ge, H.; Wu, M.; Zhang, J.; Zhao, F.; et al. Overexpression of Poplar Pyrabactin Resistance-Like Abscisic Acid Receptors Promotes Abscisic Acid Sensitivity and Drought Resistance in Transgenic Arabidopsis. PLoS ONE 2016, 11, e0168040. [Google Scholar] [CrossRef]
- Guo, D.; Zhou, Y.; Li, H.-L.; Zhu, J.-H.; Wang, Y.; Chen, X.-T.; Peng, S.-Q. Identification and characterization of the abscisic acid (ABA) receptor gene family and its expression in response to hormones in the rubber tree. Sci. Rep. 2017, 7, srep45157. [Google Scholar] [CrossRef]
- Wang, Z.; Zhou, J.; Zou, J.; Yang, J.; Chen, W. Characterization of PYL gene family and identification of HaPYL genes response to drought and salt stress in sunflower. PeerJ 2024, 12, e16831. [Google Scholar] [CrossRef] [PubMed]
- Park, S.-Y.; Fung, P.; Nishimura, N.; Jensen, D.R.; Fujii, H.; Zhao, Y.; Lumba, S.; Santiago, J.; Rodrigues, A.; Chow, T.-f.F.; et al. Abscisic Acid Inhibits Type 2C Protein Phosphatases via the PYR/PYL Family of START Proteins. Science 2009, 324, 1068–1071. [Google Scholar] [CrossRef]
- Santiago, J.; Dupeux, F.; Betz, K.; Antoni, R.; Gonzalez-Guzman, M.; Rodriguez, L.; Márquez, J.A.; Rodriguez, P.L. Structural insights into PYR/PYL/RCAR ABA receptors and PP2Cs. Plant Sci. 2012, 182, 3–11. [Google Scholar] [CrossRef]
- Iyer, L.M.; Koonin, E.V.; Aravind, L. Adaptations of the helix-grip fold for ligand binding and catalysis in the START domain superfamily. Proteins Struct. Funct. Genet. 2001, 43, 134–144. [Google Scholar] [CrossRef] [PubMed]
- Ren, C.; Kuang, Y.; Lin, Y.; Guo, Y.; Li, H.; Fan, P.; Li, S.; Liang, Z. Overexpression of grape ABA receptor gene VaPYL4 enhances tolerance to multiple abiotic stresses in Arabidopsis. BMC Plant Biol. 2022, 22, 271. [Google Scholar] [CrossRef]
- Yao, P.; Zhang, C.; Bi, Z.; Liu, Y.; Liu, Z.; Wei, J.; Su, X.; Bai, J.; Cui, J.; Sun, C. Overexpression of Potato PYL16 Gene in Tobacco Enhances the Transgenic Plant Tolerance to Drought Stress. Int. J. Mol. Sci. 2024, 25, 8644. [Google Scholar] [CrossRef]
- Li, Q.; Shen, C.; Zhang, Y.; Zhou, Y.; Niu, M.; Wang, H.-L.; Lian, C.; Tian, Q.; Mao, W.; Wang, X.; et al. PePYL4 enhances drought tolerance by modulating water-use efficiency and ROS scavenging in Populus. Tree Physiol. 2023, 43, 102–117. [Google Scholar] [CrossRef]
- Wu, F.Z. Proteomic Analysis of Low Temperature Stress Responses and Chloroplast RNA Binding Proteins in Betula platyphylla. Ph.D. Thesis, Northeast Forestry University, Harbin, China, 2008. [Google Scholar]
- Lenka, S.K.; Muthusamy, S.K.; Chinnusamy, V.; Bansal, K.C. Ectopic Expression of Rice PYL3 Enhances Cold and Drought Tolerance in Arabidopsis thaliana. Mol. Biotechnol. 2018, 60, 350–361. [Google Scholar] [CrossRef]
- Zhao, Y.; Chan, Z.; Gao, J.; Xing, L.; Cao, M.; Yu, C.; Hu, Y.; You, J.; Shi, H.; Zhu, Y.; et al. ABA receptor PYL9 promotes drought resistance and leaf senescence. Proc. Natl. Acad. Sci. USA 2016, 113, 1949–1954. [Google Scholar] [CrossRef]
- Chen, Y.; Feng, L.; Wei, N.; Liu, Z.-H.; Hu, S.; Li, X.-B. Overexpression of cotton PYL genes in Arabidopsis enhances the transgenic plant tolerance to drought stress. Plant Physiol. Biochem. 2017, 115, 229–238. [Google Scholar] [CrossRef]
- Zhang, Y.; Zhao, Y.; Li, T.; Ni, C.; Han, L.; Du, P.; Xiao, K. TaPYL4, an ABA receptor gene of wheat, positively regulates plant drought adaptation through modulating the osmotic stress-associated processes. BMC Plant Biol. 2022, 22, 423. [Google Scholar] [CrossRef]
- Liu, Z.; Zhang, M.; Wang, L.; Sun, W.; Li, M.; Feng, C.; Yang, X. Genome-wide identification and expression analysis of PYL family genes and functional characterization of GhPYL8D2 under drought stress in Gossypium hirsutum. Plant Physiol. Biochem. 2023, 203, 108072. [Google Scholar] [CrossRef] [PubMed]
- Yao, P.; Zhang, C.; Sun, C.; Liu, Y.; Liu, Z.; Wei, J.; Su, X.; Bai, J.; Cui, J.; Bi, Z. The Abscisic Acid Receptor Gene StPYL8-like from Solanum tuberosum Confers Tolerance to Drought Stress in Transgenic Plants. Antioxidants 2024, 13, 1088. [Google Scholar] [CrossRef]
- Zhang, G.; Lu, T.; Miao, W.; Sun, L.; Tian, M.; Wang, J.; Hao, F. Genome-wide identification of ABA receptor PYL family and expression analysis of PYLs in response to ABA and osmotic stress in Gossypium. PeerJ 2017, 5, e4126. [Google Scholar] [CrossRef]
- Wang, Y.; Zhang, G.; Zhou, H.; Yin, S.; Li, Y.; Ma, C.; Chen, P.; Sun, L.; Hao, F. GhPYL9-5D and GhPYR1-3 A positively regulate Arabidopsis and cotton responses to ABA, drought, high salinity and osmotic stress. BMC Plant Biol. 2023, 23, 310. [Google Scholar] [CrossRef] [PubMed]
- Giricz, O.; Lauer-Fields, J.L.; Fields, G.B. The normalization of gene expression data in melanoma: Investigating the use of glyceraldehyde 3-phosphate dehydrogenase and 18S ribosomal RNA as internal reference genes for quantitative real-time PCR. Anal. Biochem. 2008, 380, 137–139. [Google Scholar] [CrossRef] [PubMed]
- Livak, K.J.; Schmittgen, T.D. Analysis of Relative Gene Expression Data Using Real-Time Quantitative PCR and the 2−ΔΔCT Method. Methods 2001, 25, 402–408. [Google Scholar] [CrossRef]

| Gene Name | Locus Name Phytozome v13 | Genomic Sequence (bp) | Amino Acid No. | Molecular Weight (Da) | Isoelectric Points | GRAVY | Aliphatic Index | Chromosome Location | Cellular Localization |
|---|---|---|---|---|---|---|---|---|---|
| BpPYL1 | BPChr01G05180 | 510 | 170 | 18,864.43 | 4.71 | −0.203 | 85.38 | Chr01:10459086..10459596 (−) | Cytoplasm |
| BpPYL2 | BPChr01G05173 | 448 | 129 | 14,432.06 | 4.81 | −0.444 | 70.00 | Chr01:10462133..10462581 (−) | Chloroplast |
| BpPYL3 | BPChr01G05283 | 510 | 170 | 18,882.51 | 4.60 | −0.178 | 93.55 | Chr01:10474336..10474846 (−) | Chloroplast, Cytoplasm |
| BpPYL4 | BPChr01G05229 | 5197 | 198 | 22,234.06 | 5.20 | −0.252 | 77.66 | Chr01:10493852..10499049 (−) | Cytoplasm |
| BpPYL5 | BPChr06G29476 | 7591 | 186 | 20,892.77 | 6.65 | −0.352 | 87.84 | Chr06:6771830..6779421 (+) | Chloroplast |
| BpPYL6 | BPChr06G30627 | 603 | 201 | 21,820.67 | 6.49 | −0.179 | 87.55 | Chr06:36934328..36934931 (+) | Cytoplasm |
| BpPYL7 | BPChr07G10003 | 519 | 173 | 19,074.71 | 5.17 | −0.154 | 82.03 | Chr07:24448929..24449448 (−) | Chloroplast, Cytoplasm |
| BpPYL8 | BPChr08G24195 | 3192 | 163 | 18,400.18 | 5.40 | −0.091 | 106.42 | Chr08:426381..429573 (−) | Chloroplast, Nucleus |
| BpPYL9 | BPChr08G27487 | 507 | 169 | 18,676.02 | 4.53 | −0.319 | 75.42 | Chr08:11935085..11935592 (+) | Cytoplasm |
| BpPYL10 | BPChr11G06966 | 507 | 169 | 18,676.02 | 4.53 | −0.319 | 75.42 | Chr11:9495928..9496435 (−) | Cytoplasm |
| BpPYL11 | BPChr12G11482 | 3592 | 296 | 32,794.00 | 6.76 | −0.471 | 77.56 | Chr12:238375..241967 (+) | Cytoplasm, Nucleus |
| BpPYL12 | BPChr14G02044 | 624 | 208 | 22,530.36 | 6.18 | −0.136 | 88.36 | Chr14:2347659..2348283 (−) | Cytoplasm |
| Duplicated Gene Pairs | Ka | Ks | Ka/Ks | Effective Length |
|---|---|---|---|---|
| BpPYL5/BpPYL8 | 0.150212211 | 1.199074478 | 0.125273462 | 480 |
| BpPYL9/BpPYL10 | 0 | 0 | -- | 504 |
Disclaimer/Publisher’s Note: The statements, opinions and data contained in all publications are solely those of the individual author(s) and contributor(s) and not of MDPI and/or the editor(s). MDPI and/or the editor(s) disclaim responsibility for any injury to people or property resulting from any ideas, methods, instructions or products referred to in the content. |
© 2024 by the authors. Licensee MDPI, Basel, Switzerland. This article is an open access article distributed under the terms and conditions of the Creative Commons Attribution (CC BY) license (https://creativecommons.org/licenses/by/4.0/).
Share and Cite
Yu, J.; Wang, R.; Zhang, X.; Chen, S. Genome-Wide Analysis of the PYL Gene Family in Betula platyphylla and Its Responses to Abiotic Stresses. Int. J. Mol. Sci. 2024, 25, 13728. https://doi.org/10.3390/ijms252413728
Yu J, Wang R, Zhang X, Chen S. Genome-Wide Analysis of the PYL Gene Family in Betula platyphylla and Its Responses to Abiotic Stresses. International Journal of Molecular Sciences. 2024; 25(24):13728. https://doi.org/10.3390/ijms252413728
Chicago/Turabian StyleYu, Jiajie, Ruiqi Wang, Xiang Zhang, and Su Chen. 2024. "Genome-Wide Analysis of the PYL Gene Family in Betula platyphylla and Its Responses to Abiotic Stresses" International Journal of Molecular Sciences 25, no. 24: 13728. https://doi.org/10.3390/ijms252413728
APA StyleYu, J., Wang, R., Zhang, X., & Chen, S. (2024). Genome-Wide Analysis of the PYL Gene Family in Betula platyphylla and Its Responses to Abiotic Stresses. International Journal of Molecular Sciences, 25(24), 13728. https://doi.org/10.3390/ijms252413728

